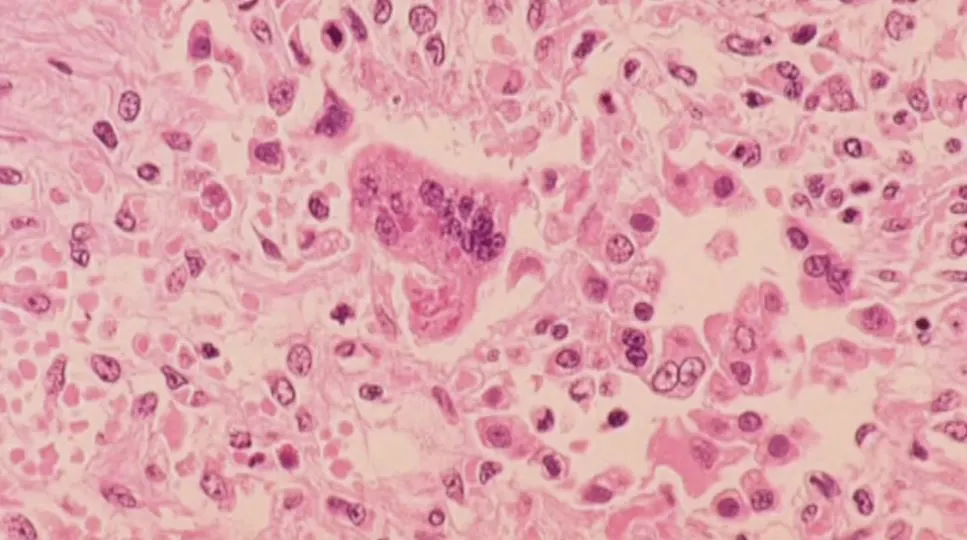
Masernkomplikationen und die Bedeutung der Impfung

Fachärzte für Innere Medizin haben gewarnt, dass die Masern, bekannt für ihre Fähigkeit zur Selbstheilung bei Personen mit gutem Immunsystem, zu schweren Komplikationen bei Personen führen können, die an einem geschwächten Immunsystem leiden. Diese Warnung wurde während eines medizinischen Kongresses in Jakarta ausgesprochen, wo Dr. Adito Susilo, Mitglied der indonesischen Gesellschaft für Innere Medizin, die Bedeutung des Bewusstseins für die Risiken der Krankheit betonte.
Dr. Susilo wies darauf hin, dass die am stärksten gefährdeten Gruppen Personen sind, die unter Mangelernährung leiden, Menschen mit Immunstörungen wie HIV, Patienten, die eine Chemotherapie erhalten, sowie schwangere Frauen. Er erklärte, dass Masern mehrere Organe im Körper betreffen können, was das Risiko von Komplikationen wie Lungenentzündung und Gehirnentzündungen erhöht.
Bedeutung der Impfung zur Prävention von Masern
Im Rahmen des Kongresses wurde die Bedeutung von Impfungen als wirksame Methode zur Prävention von Masern hervorgehoben. Dr. Susilo betonte, dass Impfungen helfen, eine starke Immunität aufzubauen, bevor man dem Virus ausgesetzt wird. Er wies auch darauf hin, dass es dringend notwendig ist, die Impfquote unter den Gruppen zu erhöhen, die nicht vollständig geimpft sind, um die Verbreitung der Krankheit zu verringern.
Der Kongress behandelte auch die frühen Symptome der Krankheit, die oft unauffällig sind, was es notwendig macht, sie frühzeitig zu erkennen, um Komplikationen zu vermeiden. Es wurde betont, dass die Behandlung auf der Unterstützung der Symptome basiert, da es keine spezifische antivirale Behandlung für Masern gibt, was die Bedeutung der Prävention durch Impfungen unterstreicht.
Hintergrund und Kontext
Historisch gesehen waren Masern eine häufige Krankheit, die Kinder betraf, aber mit dem Fortschritt der Impfprogramme sind die Infektionsraten in vielen Ländern erheblich gesunken. Dennoch bleibt die Krankheit in einigen Regionen eine Bedrohung, insbesondere unter gefährdeten Gruppen. In den letzten Jahren haben einige Länder einen Anstieg der Masernfälle erlebt, was Besorgnis unter Ärzten und Gesundheitsbehörden ausgelöst hat.
Masern gelten als hoch ansteckende Krankheit, die durch die Luft und Tröpfchen verbreitet wird, was es notwendig macht, das Bewusstsein für die Bedeutung von Impfungen zu stärken. Studien haben gezeigt, dass Impfungen das Risiko, an Masern zu erkranken, um bis zu 95 % reduzieren können, was zur Gesundheit der gesamten Gemeinschaft beiträgt.
Folgen und Auswirkungen
Das Unterlassen präventiver Maßnahmen wie Impfungen kann zu einem Anstieg der Masernfälle führen, was zusätzlichen Druck auf die Gesundheitssysteme ausübt. Auch die möglichen Komplikationen wie Lungenentzündung und Gehirnentzündungen können zu schwerwiegenden Folgen führen, einschließlich des Todes in seltenen Fällen.
Diese Warnungen sind ein Aufruf an die Gesundheitsbehörden, die Impfprogramme zu verstärken und das Bewusstsein in der Öffentlichkeit über die Risiken von Masern zu erhöhen. Es besteht auch ein dringender Bedarf, Unterstützung für immungeschwächte Personen bereitzustellen, um deren Sicherheit zu gewährleisten.
Regionale Bedeutung der Masern
In der arabischen Region stellen Masern nach wie vor eine gesundheitliche Herausforderung dar, da einige Länder in den letzten Jahren einen Anstieg der Infektionsfälle verzeichnet haben. Die Stärkung der Impfprogramme ist entscheidend, um die Verbreitung der Krankheit zu verringern und gefährdete Gruppen zu schützen.
Diese Situation erfordert eine Zusammenarbeit zwischen Regierungen, Gesundheitsbehörden und der Zivilgesellschaft, um die notwendigen Impfstoffe bereitzustellen und das Gesundheitsbewusstsein zu fördern. Investitionen in Impfprogramme können zur Verbesserung der öffentlichen Gesundheit beitragen und die mit Masern verbundenen Risiken verringern.